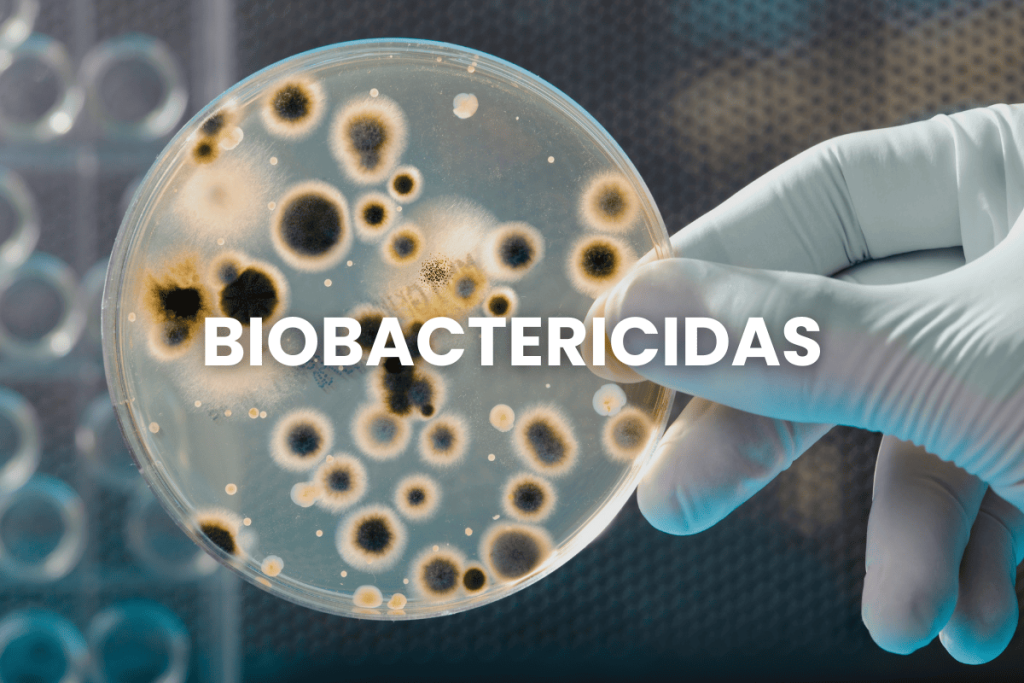

Producimos, distribuimos y comercializamos microorganismos con potencial de biocontrol,
Para Colombia y el Mundo

Línea Agrícola
• Clínica y diagnosis
• Microbiología del suelo
• Microbiología de agua
• Análisis microbiológico de compostaje
• Revalorización de residuos orgánicos
• Diagnosis en enfermedades del cultivo
• Control de insectos plaga
• Tratamiento de aguas residuales
• Biorremediación de suelos
Línea Pecuaria
• Biocontrol de enfermedades y plagas en Pasturas
• Biocontrol de garrapatas
• Fertilización biológica de Pasturas
• Ensilajes y henificación
• Control de moscas y olores en explotaciones pecuarias
• Usos de prebióticos y probióticos en nutrición animal


Documentación Legal

¡Regístrate para recibir nuestro boletín informativo, enterarte de eventos y obtener descuentos!